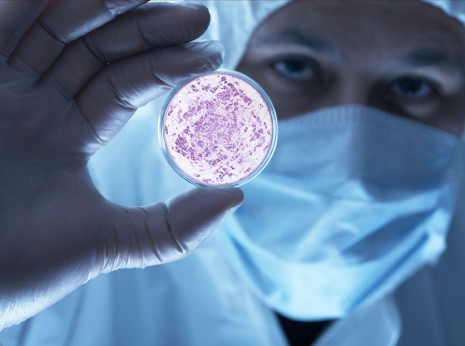
Az őssejt rózsaszínes festődése

Hírek - Címlapon
Hírek - Címlapon
Őssejtes kezelések már az állatgyógyászatban is
Az MSCell4Vet Laboratórium fejlesztése
2015. július 01., 06:00
Szerző: B.Zsófi
Kategória: Egészség
Magyar fejlesztéssel elérhetővé vált, kutyáink ízületi betegségeinek leküzdése, akár hosszú távon is. Korábban is alkalmazták az őssejteket állatgyógyászatban, de azok csak időszakosan, néhány hónapra, vagy évre oldották meg a problémát.
Az őssejt minden emlős szervezetében megtalálható. Más sejtektől való eltérésük mindössze abban mutatkozik meg, hogy mitotikus osztódással képesek a szervezet különböző funkcióit ellátó sejtekké differenciálódni. Két fajtájuk ismeretes. Az egyik a hólyagcsíra, vagy embrionális korban kialakuló embrionális őssejt, a másik pedig a felnőtt, vagy szöveti őssejt.
Forrás: http://cbc.hu/
Az új fejlesztésben az őssejtek ezen változékonyságát felhasználva, zsírszövetből kivont állományból alakítottak ki csont, ín, izom, és porcszövetet. A felnőtt őssejtek megoldást nyújtanak könyök- és csípőízületi diszpláziára, arthrózisra, törésre, és teljes ínszalag szakadásra is. A gyógyulási idő viszonylag rövid, ugyanis az őssejtek gyulladáscsökkentő hatásúak. Ezt a tulajdonságot figyelembe véve állítható, hogy egyik egyedből a másikba oltva sem lökődnek ki a szervezetből, valamint ennek a tulajdonságnak az ismeretével válhatott valóra a fejlesztés.
Míg korábban ugyanazon egyedekből vették le a beoltandó anyagot, úgy most eltérőek a donorok. Ennek lényege, hogy nem a genetikai hibát hordozó őssejtet ültetik be a kutyába, hanem egy egészséges egyed őssejtjeit. Ez akár az eb egész életére pontot tehet az ízületi problémák végére.
A könyökízületi diszplázia évente körülbelül száz kutyát érint országosan. 4-6 hónapos korban alakul ki, így megpecsételi az állat további életét. Ha a kezelést választjuk részleges, vagy akár teljes gyógyulásnak is tanúi lehetünk. Az eljárás egyszerű. Őssejteket juttatnak a kezelni kívánt ízületbe, vagy ízület mellé, ahol azok olyan sejtté alakulnak, amilyenre a szervezetnek szüksége van. Kockázata minimális (ellenben a műtétekkel), súlyos mellékhatása nem ismert.

Forrás: http://www.allatkorhaznyiregyhaza.hu/
Az ára sajnos elég magas, de fiatal kutyánál még így is érdemes elgondolkodni a beavatkozáson. Érdeklődni az Őssejt Laboratórium honlapján lehetséges a megadott, és a kezelést is végző állatorvosoknál. Az MSCell4Vet-et már a Facebook-on is elérhitek!
Ha tetszett a cikk, és szeretnél értesülni legújabb híreinkről
kérünk lájkold Facebook oldalunkat!
Forrás: allatkorhaznyiregyhaza.hu
Indexkép forrás: cdn.nocamels.com
 Miért félnek egyes kutyák a hangos zajoktól és a tűzijátéktól, míg mások nem?
Miért félnek egyes kutyák a hangos zajoktól és a tűzijátéktól, míg mások nem?
Tomboló vihar nyáron, tűzijáték ünnepségekkor és újévkor… Rengeteg kutyát tölt el rettegéssel a velük járó hangzavar, de akadnak olyanok is, akiknek szinte fel sem tűnik, hogy mi zajlik körülöttük. Érdekes eredményeket mutatnak a kutatások is!
 A kutyák is tudatában vannak cselekvéseiknek egy új kutatás szerint
A kutyák is tudatában vannak cselekvéseiknek egy új kutatás szerint
A kutyák képesek visszaemlékezni az általuk korábban végrehajtott tevékenységekre, vagyis tudatában vannak bizonyos cselekvéseiknek, derül ki az ELTE Etológia Tanszék kutatóinak a Scientific Reports című folyóiratban publikált legújabb kutatásából.
 Miért támasztja a fejét a falnak? - “Head pressing”
Miért támasztja a fejét a falnak? - “Head pressing”
Érdemes utánajárni a betegség kezdeti tüneteinek, ugyanis a fej lógatásáig jutott kórt már igen nehéz kezelni. Ha bármikor látjuk, hogy kutyánk a falat támasztja azonnal forduljunk állatorvoshoz!
 Édes a pihenés - Ezért fontos kutyáknál is a jó (sok) alvás
Édes a pihenés - Ezért fontos kutyáknál is a jó (sok) alvás
A jó alvás fél egészség, márpedig napjaink felgyorsult világában a kutyáknak is nehézséget okozhat kellően kipihenni magukat. Hogyan segíthetünk kedvenceinknek?
 Mit tegyek, ha a kutyám állandóan nyalogatja a mancsát?
Mit tegyek, ha a kutyám állandóan nyalogatja a mancsát?
Természetes, hogy kedvencünk időről-időre megtisztogatja a mancsait, ám a túlzásba vitt nyalogatás, rágcsálás komolyabb problémát is elfedhet, melyet érdemes kivizsgáltatni.











